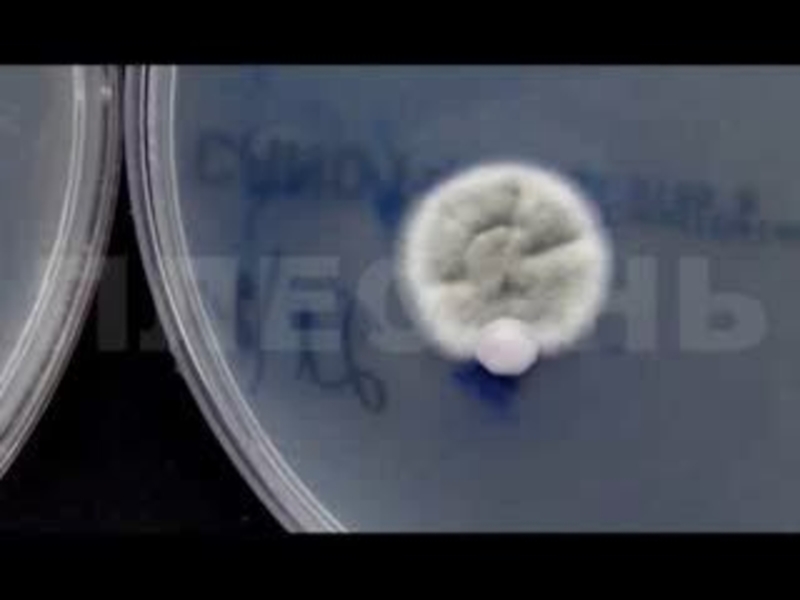
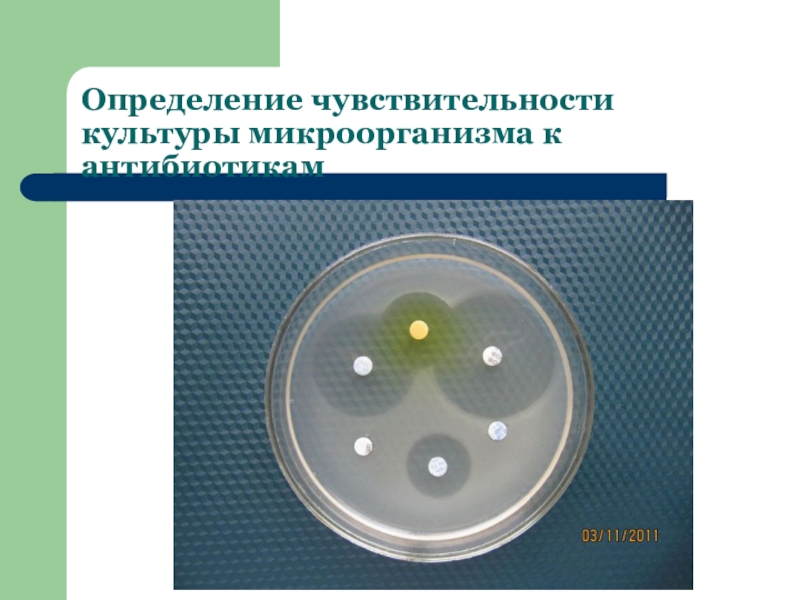
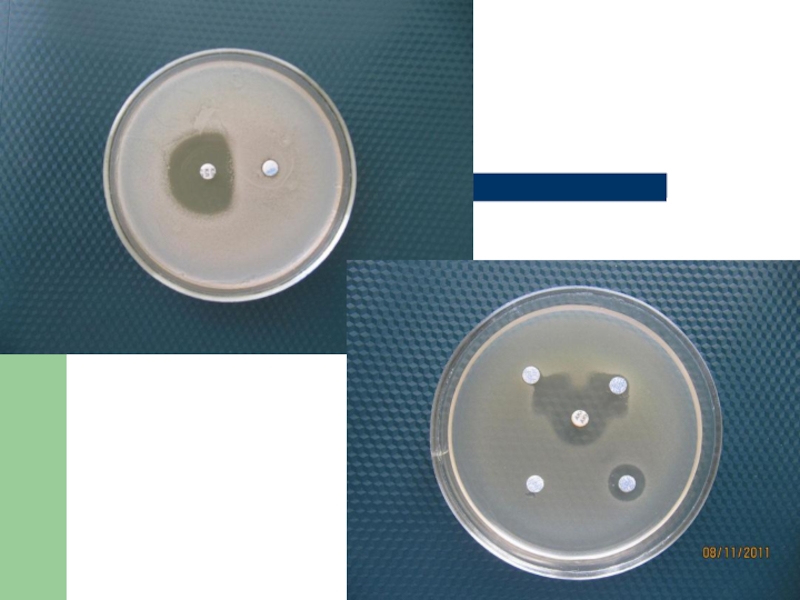
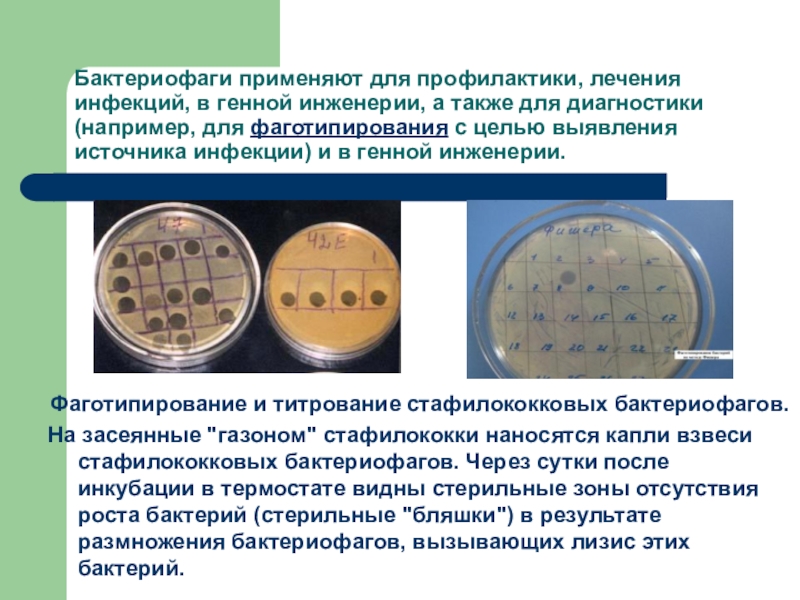

антибиотиков.
Бактериофаги.
- Главная
- Разное
- Образование
- Спорт
- Естествознание
- Природоведение
- Религиоведение
- Французский язык
- Черчение
- Английский язык
- Астрономия
- Алгебра
- Биология
- География
- Геометрия
- Детские презентации
- Информатика
- История
- Литература
- Математика
- Музыка
- МХК
- Немецкий язык
- ОБЖ
- Обществознание
- Окружающий мир
- Педагогика
- Русский язык
- Технология
- Физика
- Философия
- Химия
- Шаблоны, фоны, картинки для презентаций
- Экология
- Экономика
Презентация, доклад Микробиологические основы химиопрофилактики и химиотерапии инфекционных болезней. Бактериофаги.
Содержание
- 1. Презентация Микробиологические основы химиопрофилактики и химиотерапии инфекционных болезней. Бактериофаги.
- 2. Химиотерапияиспользование природных и синтезированных химических соединений для лечения инфекционных и неинфекционных заболеваний.
- 3. Требования к химиопрепаратам:Минимальная органотропностьМаксимальная этиотропностьЭтиоспецифичность
- 4. Химиотерапевтический индекс.Представляет собой соотношение двух доз препарата
- 5. Химиотерапевтические препаратыПрепараты мышьяка Препараты висмута Препараты ртути Препараты сурьмы
- 6. Сульфаниламидные препараты.Сульфаниламиды общего действия Сульфаниламиды, медленно и
- 7. Антибиотики.«Специфические продукты жизнедеятельности организмов или их модификации,
- 8. Слайд 8
- 9. Слайд 9
- 10. Слайд 10
- 11. Признаки антибиотиковантибиотики – конечные продукты обмена,
- 12. За единицу антибиотической активности принимают: минимальное количество
- 13. Классификация антибиотиков по происхождениюБактериального происхождения Образуемые актиномицетами
- 14. Классификация антибиотиков по механизму действия
- 15. Действие пенициллина
- 16. Классификация антибиотиков по спектру биологического действияПротивобактериальные антибиотики
- 17. Классификация антибиотиков по химическому строению Ациклического строения,
- 18. Определение чувствительности культуры микроорганизма к антибиотикам
- 19. Слайд 19
- 20. ПОБОЧНОЕ ДЕЙСТВИЕ АНТИБИОТИКОВ И МЕТОДЫ БОРЬБЫ С
- 21. БАКТЕРИОФАГ, ЕГО ПРИРОДА И ПРАКТИЧЕСКОЕ ИСПОЛЬЗОВАНИЕ.Вирус, поражающий бактерии
- 22. Слайд 22
- 23. Взаимодействие бактериофага с оболочкой бактерии.
- 24. Виды фаговполивалентные фаги, способные вызывать лизис группы
- 25. По способу взаимодействия с клеткой-хозяином фаги делятся
- 26. Бактериофаги применяют для профилактики, лечения инфекций, в
Химиотерапияиспользование природных и синтезированных химических соединений для лечения инфекционных и неинфекционных заболеваний.
Слайд 1ХИМИОТЕРАПЕВТИЧЕСКИЕ ПРЕПАРАТЫ. АНТИБИОТИКИ. БАКТЕРИОФАГИ.
Понятие о химиотерапии.
Сульфаниламиды.
Понятие об антибиотиках.
Принципы классификации антибиотиков.
Побочное действие
Слайд 2Химиотерапия
использование природных и синтезированных химических соединений для лечения инфекционных и неинфекционных
заболеваний.
Слайд 3Требования к химиопрепаратам:
Минимальная органотропность
Максимальная этиотропность
Этиоспецифичность
Слайд 4Химиотерапевтический индекс.
Представляет собой соотношение двух доз препарата – максимально переносимой и
минимальной лечебной и должен быть не менее трех.
MAX перенос.>3
MIN лечебн.
MAX перенос.>3
MIN лечебн.
Слайд 5Химиотерапевтические препараты
Препараты мышьяка
Препараты висмута
Препараты ртути
Препараты сурьмы
Слайд 6Сульфаниламидные препараты.
Сульфаниламиды общего действия
Сульфаниламиды, медленно и плохо всасывающиеся из желудочно-кишечного
тракта
Сульфаниламиды, выделяющиеся в основном почками
Салазосульфаниламиды
Группа сульфаниламидов, используемых наружно в виде эмульсий, мазей, порошков, присыпок и т.д.
Сульфаниламиды, выделяющиеся в основном почками
Салазосульфаниламиды
Группа сульфаниламидов, используемых наружно в виде эмульсий, мазей, порошков, присыпок и т.д.
Слайд 7Антибиотики.
«Специфические продукты жизнедеятельности организмов или их модификации, обладающие высокой физиологической активностью
по отношению к определенным группам микроорганизмов или злокачественным опухолям, избирательно задерживая их рост или подавляя развитие»
Н.С. Егоров.
Н.С. Егоров.
Слайд 11Признаки
антибиотиков
антибиотики – конечные продукты обмена, по биологическим свойствам являющиеся антиметаболитами,
антибиотики
обладают высокой биологической активностью по отношению к чувствительным к ним организмам,
антибиотикам присуща избирательность действия.
Относительная безвредность для человека и животных отличает антибиотики от общебиологических ядов.
антибиотикам присуща избирательность действия.
Относительная безвредность для человека и животных отличает антибиотики от общебиологических ядов.
Слайд 12За единицу антибиотической активности принимают:
минимальное количество антибиотика, способное подавить развитие
или задержать рост определенного числа клеток стандартного тест-штамма микроорганизма в единице объема питательной среды.
Слайд 13Классификация антибиотиков по происхождению
Бактериального происхождения
Образуемые актиномицетами
Образуемые совершенными грибами
Образуемые
лишайниками, водорослями, низшими растениями
Образуемые высшими растениями
Животного происхождения
Образуемые высшими растениями
Животного происхождения
Слайд 16Классификация антибиотиков по спектру биологического действия
Противобактериальные антибиотики узкого спектра действия, активные
в отношении Г+ или Г- бактерий
Противобактериальные антибиотики широкого спектра действия, активные в отношении Г+ и Г- бактерий
Противотуберкулезные антибиотики
Противогрибквые антибиотики
Противоопухолевые
Противоамебные
Противобактериальные антибиотики широкого спектра действия, активные в отношении Г+ и Г- бактерий
Противотуберкулезные антибиотики
Противогрибквые антибиотики
Противоопухолевые
Противоамебные
Слайд 17Классификация антибиотиков по химическому строению
Ациклического строения,
алициклического строения,
ароматические,
тетрациклины,
хиноны,
содержащие
кислород-гетероциклические соединения,
олигомицины,
макролиды,
аминогликозиды,
содержащие азот-гетероциклические соединения,
полипептиды,
дипсипептиды,
актиномицины,
стрептомицины,
металлсодеожащие соединения.
олигомицины,
макролиды,
аминогликозиды,
содержащие азот-гетероциклические соединения,
полипептиды,
дипсипептиды,
актиномицины,
стрептомицины,
металлсодеожащие соединения.
Слайд 20ПОБОЧНОЕ ДЕЙСТВИЕ АНТИБИОТИКОВ И МЕТОДЫ БОРЬБЫ С НИМ.
Развитие аллергических явлений
Реакция обострения
Нарушение
формирования полноценного иммунитета
Дисбактериозы
Прямые токсические органотропные реакции.
Влияние на развитие плода.
Дисбактериозы
Прямые токсические органотропные реакции.
Влияние на развитие плода.
Слайд 24Виды фагов
поливалентные фаги, способные вызывать лизис группы бактерий
моновалентные фаги, лизирующие культуры
бактерий определённого вида
типовые фаги, лизирующие отдельные типы внутри вида
типовые фаги, лизирующие отдельные типы внутри вида
Слайд 26Бактериофаги применяют для профилактики, лечения инфекций, в генной инженерии, а также
для диагностики (например, для фаготипирования с целью выявления источника инфекции) и в генной инженерии.
Фаготипирование и титрование стафилококковых бактериофагов.
На засеянные "газоном" стафилококки наносятся капли взвеси стафилококковых бактериофагов. Через сутки после инкубации в термостате видны стерильные зоны отсутствия роста бактерий (стерильные "бляшки") в результате размножения бактериофагов, вызывающих лизис этих бактерий.